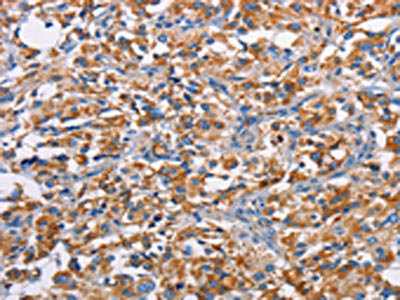

PIM2 Antibody
-
中文名稱:PIM2兔多克隆抗體
-
貨號(hào):CSB-PA545216
-
規(guī)格:¥1100
-
圖片:
-
其他:
產(chǎn)品詳情
-
Uniprot No.:
-
基因名:PIM2
-
別名:OTTHUMP00000025825 antibody; Pim 2 oncogene antibody; Pim 2h antibody; Pim-2h antibody; PIM2 antibody; PIM2 Oncogene antibody; PIM2_HUMAN antibody; Pim2h antibody; Proto Oncogene PIM2 antibody; Proto-oncogene Pim-2 (serine threonine kinase) antibody; Serine/threonine kinase PIM2 antibody; Serine/threonine-protein kinase Pim-2 antibody
-
宿主:Rabbit
-
反應(yīng)種屬:Human,Mouse
-
免疫原:Fusion protein of Human PIM2
-
免疫原種屬:Homo sapiens (Human)
-
標(biāo)記方式:Non-conjugated
-
抗體亞型:IgG
-
純化方式:Antigen affinity purification
-
濃度:It differs from different batches. Please contact us to confirm it.
-
保存緩沖液:-20°C, pH7.4 PBS, 0.05% NaN3, 40% Glycerol
-
產(chǎn)品提供形式:Liquid
-
應(yīng)用范圍:ELISA,IHC
-
推薦稀釋比:
Application Recommended Dilution ELISA 1:1000-1:5000 IHC 1:50-1:200 -
Protocols:
-
儲(chǔ)存條件:Upon receipt, store at -20°C or -80°C. Avoid repeated freeze.
-
貨期:Basically, we can dispatch the products out in 1-3 working days after receiving your orders. Delivery time maybe differs from different purchasing way or location, please kindly consult your local distributors for specific delivery time.
-
用途:For Research Use Only. Not for use in diagnostic or therapeutic procedures.
相關(guān)產(chǎn)品
靶點(diǎn)詳情
-
功能:Proto-oncogene with serine/threonine kinase activity involved in cell survival and cell proliferation. Exerts its oncogenic activity through: the regulation of MYC transcriptional activity, the regulation of cell cycle progression, the regulation of cap-dependent protein translation and through survival signaling by phosphorylation of a pro-apoptotic protein, BAD. Phosphorylation of MYC leads to an increase of MYC protein stability and thereby an increase transcriptional activity. The stabilization of MYC exerted by PIM2 might explain partly the strong synergism between these 2 oncogenes in tumorigenesis. Regulates cap-dependent protein translation in a mammalian target of rapamycin complex 1 (mTORC1)-independent manner and in parallel to the PI3K-Akt pathway. Mediates survival signaling through phosphorylation of BAD, which induces release of the anti-apoptotic protein Bcl-X(L)/BCL2L1. Promotes cell survival in response to a variety of proliferative signals via positive regulation of the I-kappa-B kinase/NF-kappa-B cascade; this process requires phosphorylation of MAP3K8/COT. Promotes growth factor-independent proliferation by phosphorylation of cell cycle factors such as CDKN1A and CDKN1B. Involved in the positive regulation of chondrocyte survival and autophagy in the epiphyseal growth plate.
-
基因功能參考文獻(xiàn):
- Inhibition of PIM2 attenuated asthma symptoms and increased expression levels of interleukin (IL)10 and forkhead box protein 3 (FOXP3) in bronchoalveolar lavage fluid. PMID: 28944837
- data suggest that PIM1/2 kinase overexpression is a common feature of male reproductive organs tumors, which provoke tissue alterations and a large inflammatory response that may act synergistically during the process of tumorigenesis. PMID: 27901106
- show that PIM1 contributes to melanoma cell proliferation and tumor growth in vivo; however, the presence of PIM2 and PIM3 could also influence the outcome. PMID: 27448973
- the elevated expression of PIM2 in blastic cells is associated with poor prognosis of AML patients and their resistance to induction therapy. PMID: 26764044
- Our data provide evidence for a novel role for Pim2 in the regulation of the DNA damage response (DDR). Knockdown of Pim2 upregulates several downstream DDR markers, mimicking the effects of doxorubicin (Dox) treatment of MM cells, and suggesting a role for the kinase as a negative regulator of this pathway. PMID: 27564460
- These results demonstrate the involvement of PIM kinases in LIF-induced regulation in different trophoblastic cell lines which may indicate similar functions in primary cells. PMID: 28729093
- PIM kinases in classical Hodgkin lymphoma exhibit pleiotropic effects, orchestrating tumor immune escape and supporting Reed-Sternberg cell survival. PMID: 28698206
- High PIM2 expression is associated with osteosarcoma. PMID: 27826617
- We show that Pim2 inhibitors and proteasome inhibitors, such as bortezomib, have additive effects to inhibit the growth of myeloma cells, suggesting that Pim2 could be an interesting target for the treatment of multiple myeloma. PMID: 26500282
- PIM2 gene knockdown enhances the anti-proliferative effect of AZD1208 in non-Hodgkin lymphoma cell line. PMID: 26643319
- A high percentage of urothelial carcinomas express Pim kinases. Pim expression differs in NILG, NIHG, and IHG lesions. PMID: 26551340
- Our findings suggest that Pim-2-mediated aerobic glycolysis is critical for monitoring Warburg effect in colorectal tumor cells, highlighting Pim-2 as a potential metabolic target for colorectal tumor therapy. PMID: 26078709
- our findings will help to uncover novel signaling pathways between inflammations and oxidative stress in rheumatoid arthritis development and imply that Pim-2/mTORC1 pathway may be critical for the initiation of inflammatory reactions. PMID: 26064888
- Persistent activation of STAT3 by PIM2-driven positive feedback loop for epithelial-mesenchymal transition in breast cancer. PMID: 25854938
- Data demonstrate the role of PIM kinases in driving myeloid leukemia, and as candidate molecules for therapy against human malignancies. PMID: 25238262
- Blocking the activities of PIM kinases(PIM1, PIM2 and PIM3) could prevent pancreatic cancer development. PIM kinases(PIM1, PIM2 and PIM3) may be a novel target for cancer therapy PMID: 24799066
- HIF-1A induced PIM2 expression in HepG2 cells via binding to the hypoxia-responsive elements (HREs) of the PIM2 promoter. PMID: 24505470
- PIM2 could directly phosphorylate PKM2 on the Thr-454 residue, resulting in an increase of PKM2 protein levels. Compared with wild type, PKM2 with the phosphorylation-defective mutation displayed a reduced effect on glycolysis. PMID: 24142698
- Pim2 directly phosphorylates TSC2 on Ser-1798 and relieves the suppression of TSC2 on mTOR-C1, leading to multiple myeloma cells proliferation. PMID: 23818547
- Data indicate that PIM-2 is an upstream activator of E2F-1 and ATM in the ultraviolet damage response. PMID: 23760264
- Overexpression of pim-2 may inhibit the apoptosis of prostate cancer cells through phosphorylation of eIF4B, thus promoting tumorigenesis. PMID: 23813671
- our results identify eIF4B as a critical substrate of Pim kinases in mediating the activity of Abl oncogenes PMID: 23749639
- Our data indicate that PIM-2 and NF-kappaB gene expression is increased in patients with acute myeloid leukemia and acute lymphoblastic leukemia. High PIM-2 expression is associated with complete remission rate in AML patients. PMID: 23752607
- PIM kinases promote the production of IFNgamma, the hallmark cytokine produced by Th1 cells. PMID: 23209281
- While PIM-2 can function as a potent survival factor, it can, under certain circumstances, exhibit pro-apoptotic effects as well. PMID: 22506047
- Pax-5 may act as a transcription factor to modulate the expression of Pim-2 in B-cells PMID: 21299464
- Targeting cap-dependent translation blocks converging survival signals by AKT and PIM 1, 2 kinases in lymphoma PMID: 21859846
- IL-6 and TNF family cytokines upregulate Pim-2 in bone marrow stromal cells and osteoclasts in multiple myeloma. This appears to be a novel anti-apoptotic mechanism for MM cell survival. PMID: 21475253
- A cell-based test system useful for rapid and inexpensive pre-screening of compounds capable of preventing Pim-mediated phosphorylation is discussed. PMID: 20939820
- PIM2 controls the expression of the pro-inflammatory cytokine IL-6. PMID: 20465571
- Data show that Pim-2 can induce malignant transformation of human liver cell line L02. PMID: 20592892
- we infer that Pim-2 could activate API-5 to inhibit the apoptosis of liver cells, and NF-kappaB is the key regulator PMID: 19821157
- structural analysis of the PIM2 kinase in complex with an organoruthenium inhibitor PMID: 19841674
- pim-2 functions similarly to pim-1 as a pro-survival kinase; BAD is a legitimate PIM-2 substrate PMID: 12954615
- hPim-2 mRNA expression in NHL was 1.5 to 2.6 times higher in involved splenic foci compared to nearby uninvolved regions. hPim-2 mRNA was increased 3-folds in B-CLL over normal B-cells PMID: 15291354
- transcriptional induction of Pim-2 initiates a novel NF-kappaB activation pathway that regulates cell survival PMID: 15548703
- EBV-induced upregulation of Pim kinases and Pim-stimulated EBNA2 transcriptional activity may contribute to the ability of EBV to immortalize B-cells and predispose them to malignant growth. PMID: 15721354
- Up-regulation of Pim-2 is associated with disease progression and perineural invasion in prostate cancer. PMID: 16015593
- All three Pim kinase family members predominantly phosphorylate Bad on Ser112 and in addition are capable of phosphorylating Bad on multiple sites associated with the inhibition of the pro-apoptotic function of Bad in HEK-293 cells PMID: 16403219
- expression of the Myc and Pim proto-oncogenes by Jak2V617F was found to be FERM domain dependent. PMID: 18216297
- Foxp3 can regulate pim 2 expression. PMID: 18424697
- Pim kinases promote cell cycle progression and tumorigenesis by down-regulating p27(Kip1) expression at both transcriptional and posttranslational levels. PMID: 18593906
- pim-2 acts as a pro-survival kinase to inhibit apoptosis and keep liver cell survival in IL-3-deprived medium. Pim-2 might participate in the tumorigenesis of hepatocellular carcinoma induction through its downstream molecules 4E-BP1 and Bad. PMID: 18675992
顯示更多
收起更多
-
蛋白家族:Protein kinase superfamily, CAMK Ser/Thr protein kinase family, PIM subfamily
-
組織特異性:Highly expressed in hematopoietic tissues, in leukemic and lymphoma cell lines, testis, small intestine, colon and colorectal adenocarcinoma cells. Weakly expressed in normal liver, but highly expressed in hepatocellular carcinoma tissues.
-
數(shù)據(jù)庫(kù)鏈接:
Most popular with customers
-
YWHAB Recombinant Monoclonal Antibody
Applications: ELISA, WB, IHC, IF, FC
Species Reactivity: Human, Mouse, Rat
-
-
-
-
-
-
-
VDAC1 Recombinant Monoclonal Antibody
Applications: ELISA, WB, IHC
Species Reactivity: Human, Mouse, Rat